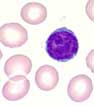

Aussehen:
Die Erythrozyten stellen quantitativ den grössten Anteil an peripheren Blutzellen. Ihr Normbereich liegt zwischen 4 und 6 x 1012/L. Erythrozyten sind leicht zu erkennen. Sie färben sich eosinophil, d.h. orange-rot, sind rund, haben eine zentrale Aufhellung und besitzen keinen Kern. Erythrozyten weisen eine hohe Uniformität auf, weshalb sie sich als Massstab für andere Zellen eignen. Im Normalfall weisen weniger als 10% eine Abweichung von Grösse, Form oder Färbung auf.
Grösse:
Erythrozyten messen im Querdurchmesser rund 7 µm. Um Abweichungen der Grösse von dieser Norm zu erkennen, kann die Grösse des Kerns eines kleinen Lymphozyten beigezogen werden. Dessen kleinster Durchmesser entspricht rund 7-8 µm.
Form:
Die Form der Erythrozyten entspricht einer Scheibe (Diskus), die in der Mitte beidseits eingedellt, also bikonkav ist. Hierdurch kommt die zentrale Aufhellung zustande.
Färbung:
Die Färbung der Erythrozyten gibt einen Hinweis auf ihre Füllung mit Hämoglobin. Normalerweise beträgt die zentrale Aufhellung 1/3 des Querdurchmessers. Beträgt der Querdurchmesser mehr als ein Drittel, so liegt eine Hypochromie vor, d.h. die Erythrozyten erscheinen heller bzw. weniger gut gefärbt. Machen die hämoglobinhaltigen Ränder zusammen weniger als 1/3 des Querdurchmessers aus, spricht man von Anulozyten. Analog zur Hypochromie gibt es auch eine Hyperchromie. Die Erythrozyten erscheinen dunkler und haben keine oder nur eine kleine zentrale Aufhelllung. Eine Hyperchromie tritt hauptsächlich bei der hereditären Spärozytose auf.
![]() |
![]() |
![]() |
| normochrom | hypochrom | hyperchrom |
|---|
Einschlüsse:
Erythrozyten haben eine homogene Zytoplasmaanfärbung. Umschriebene, meist punktförmige Veränderungen werden Einschlüsse genannt. Hierzu zählt auch das Vorliegen eines Zellkerns. Erythrozytäre Einschlüsse sind im peripheren Blut immer pathologisch.
Funktion:
Erythrozyten sind in verschiedener Hinsicht aussergewöhnliche Zellen. Neben dem Sauerstoff dienen sie vielen weiteren Molekülen als Transportvehikel. Wichtig ist hier z.B. der Transport von Immunkomplexen (an die Erythrozytenoberfläche gebunden) zu deren Abbauorten in Milz und Leber. Die spezielle Form der Erythrozyten bringt zwei entscheidende Vorteile. Einerseits entsteht so ein ideales Volumen:Oberfläche-Verhältnis, wie es für den Gasaustausch wichtig ist. Andererseits erlaubt diese Form eine starke Deformierung der Zelle, was beim Passieren durch Kapillaren von entscheidender Bedeutung ist. Die Kernlosigkeit beinhaltet ebenfalls eine Reihe von Vorteilen. So wird die Deformierbarkeit zusätzlich verbessert. Weiter wird das Herz entlastet, was folgende theoretische Rechnung veranschaulicht. Das Herz pumpt bei einer 75 kg schweren Person rund 3 kg Erythrozyten pro Minute. Da ein Zellkern mit 40 pg das Gewicht eines Erythrozyten von 100 pg fast veranderthalbfacht, entspricht dies einer Einsparung von einer bis anderthalb Tonnen pro Tag, die das Herz weniger pumpen muss.